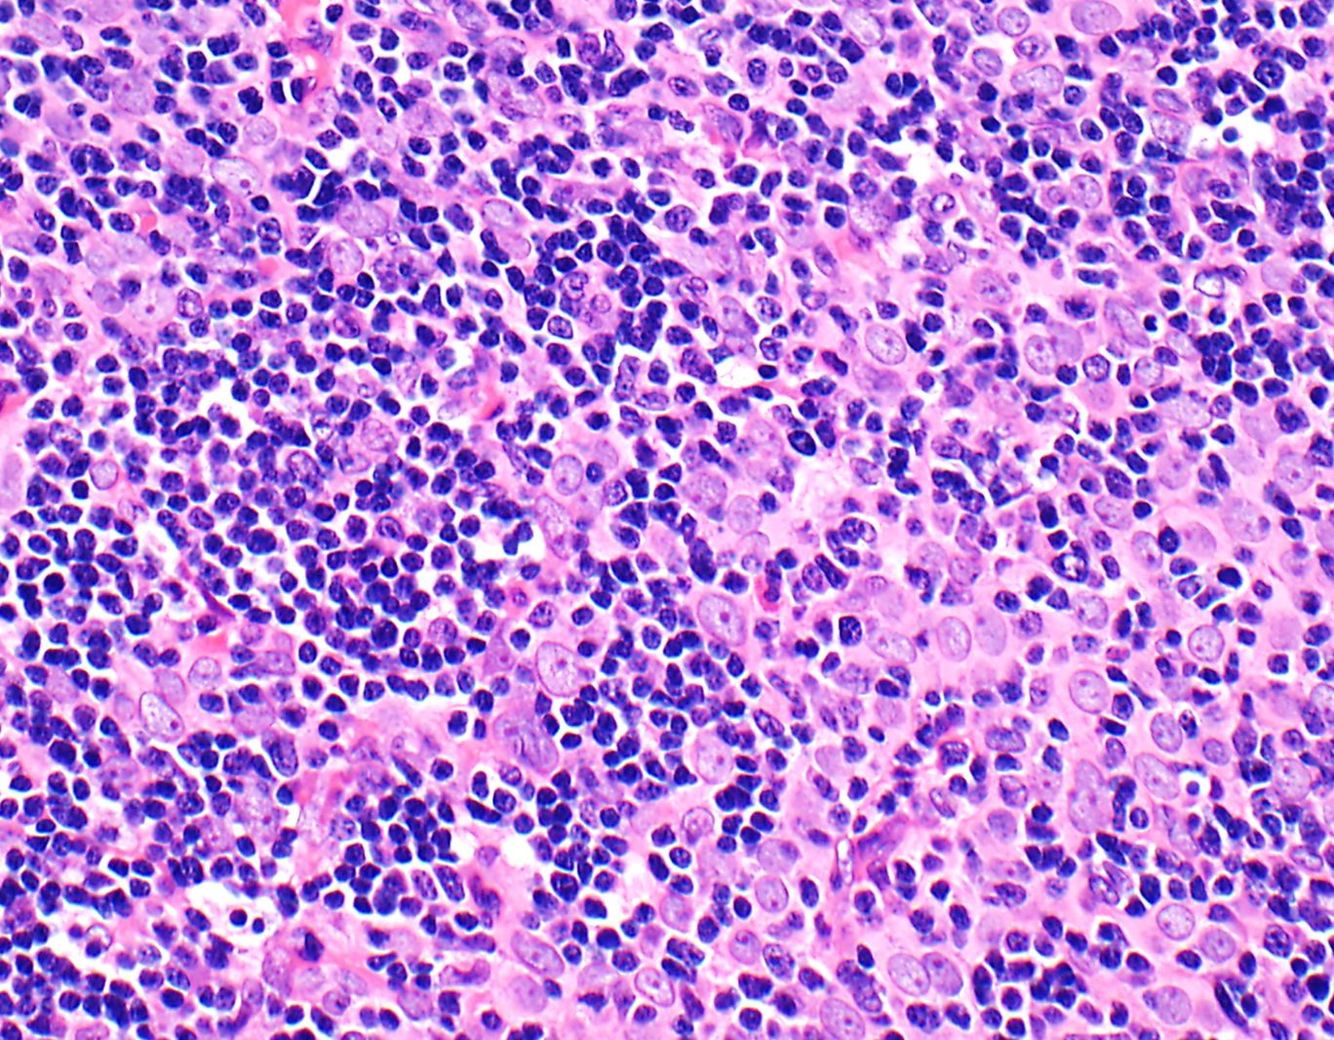
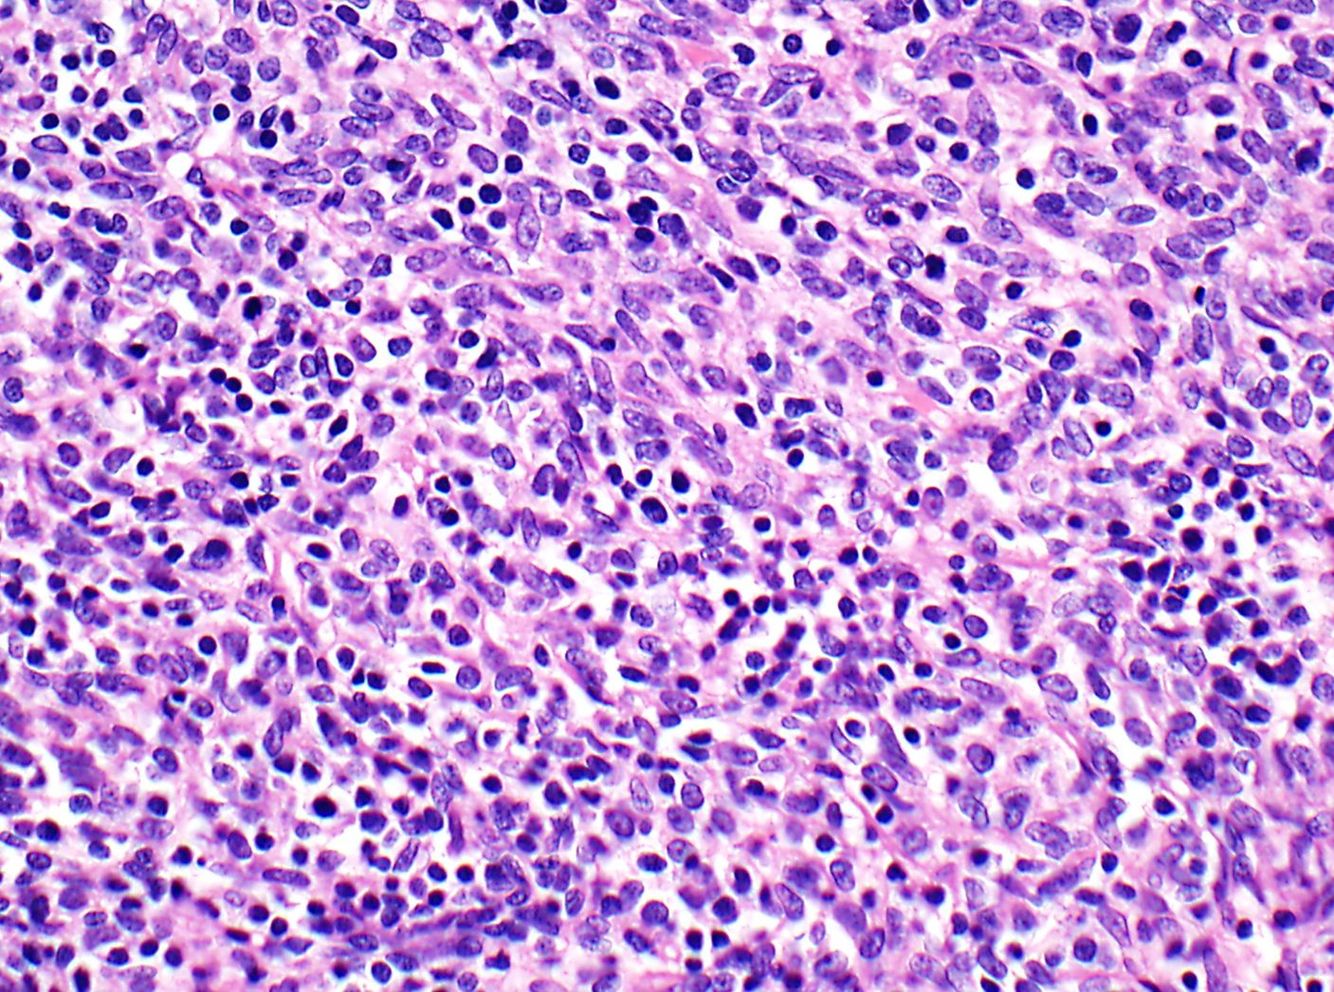

Types of thymoma
There are five different types of thymoma, which are divided into A and B based on a stromal or lymphoid-predominant pattern. Type A thymomas are stromal, while type B have lymphoid and epithelial components. In type B, B1 is the most lymphoid and B3 is the most epithelioid. The prognosis also gets worse as you go up on the B# scale.
- Type A
- Type AB (mixed)
- Type B1
- Type B2
- Type B3
Thymoma, type A
Type A thymomas are spindle cell predominant, or “medullary”.
They are full of bland spindle cells with oval nuclei, have rare or no thymocytes, and can have various patterns: hemangiopericytoma-like, vascular, rosettes/pseudorosettes, microcystic change, etc.
They should not have Hassall corpuscle-like structures / medullary islands – if this is present with a background that looks like type A, you should think type AB.
If you are in doubt, or think there may be an A-component to a mostly type B thymoma, stain with CD20 (cells of type A thymoma are often CD20+).

Thymoma, type B1
Type B1 thymomas are lymphocyte rich. They look the closest of all thymoma subtypes to regular thymoma, but are large and hypercellular, and whatever epithelial elements are left will be floating in a sea of lymphocytes.
If you see a true Hassall corpuscle, it is type B1 (or AB if there is an A component). But more often, you will just see “medullary islands” of epithelial differentiation that stain p40 and keratin positive. TdT stain will highlight the thymocytes and is very useful for picking out the nonstaining epithelial islands.

Thymoma, type B2
Type B2 thymomas are characterized by a mixed epithelial cell and lymphocyte picture.
Instead of a straight up sea of lymphocytes, these tumors have a smattering of lymphocytes and large stromal cells with prominent nucleoli. They may have some medullary island, but will not have fully differentiated Hassall corpuscles.
Thymoma, type B3
Type B3 thymomas are principally epithelial, with rare or no thymocytes. This is somewhat similar to type A, but in type B there will be an epithelial pattern as opposed to a stromal pattern in type A.
Type B3 will also be overtly neoplastic, looking nothing like the thymic tissue it arose from.

Type AB thymoma
Type AB thymomas have features of type A and either type B1 or B2 (not B3).
These type A and B elements can be either intermingled or completely separated. When they are separted, this can be a little easier to see - but when they are intermingled you will need to go to high power to try and determine if you see a stromal neoplastic component.
Here, stains are your friend. TdT, CD20, keratin, CD3 will help you separate out the components.
Thymoma perivascular spaces
xxxxxx
More commonly seen in type B thymomas.


